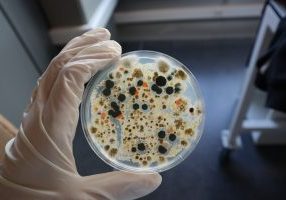
Ecoefficacy

LA AGRICULTURA DEL FUTURO

ValGenetics está comprometida con el desarrollo de una agricultura 4.0 profesionalizada, sostenible, saludable, competitiva y rentable.
Facilitamos a nuestros clientes la obtención de productos agrícolas, agroalimentarios y agrobiotecnológicos de calidad, nutritivos, compatibles con el medioambiente y con todas las garantías sanitarias.
Nuestras investigaciones y desarrollos van dirigidos a generar una agricultura con alto valor añadido.
PIONEROS EN SOLUCIONES ÚNICAS

ValGenetics ofrece soluciones globales de sanidad vegetal y genética de plantas.
Aplicamos el conocimiento académico al desarrollo de respuestas científicas a las necesidades clave para el sector agrícola, agroalimentario y biotecnológico.
Detectamos los agentes causantes de enfermedades perniciosas, asegurando el cultivo de plantas libres de patógenos. Apoyamos el desarrollo de productos bioestimulantes garantizando la trazabilidad genética de las variedades cultivadas.
INVESTIGAMOS, DESARROLLAMOS, INNOVAMOS

- Disponemos de un equipo científico-técnico multidisciplinar de expertos en Fitopatología, Microbiología, Genética, Cultivo in vitro de tejidos vegetales y Biotecnología de plantas.
- Desarrollamos metodologías de precisión diagnóstica para el control y combate de enfermedades presentes y futuras
- Estudiamos la microbiota patogénica y beneficiosa para el desarrollo de bioestimulantes efectivos y compatibles con el medio ambiente.
- Aplicamos técnicas de mejora genética para generar nuevas variedades vegetales nutritivas y adaptadas al gusto del mercado.
- Perfeccionamos nuevas metodologías de cultivo in vitro de tejidos vegetales para salvaguardar la sanidad vegetal.
- Aplicamos tecnologías ómicas y programas de análisis bioinformático para una agricultura 4.0.
- Proporcionamos servicios de consultoría técnica y desarrollo de proyectos de innovación.
Actualidad ValGenetics
-
Concedido a ValGenetics el proyecto GenoSystem Plant, una plataforma de genotipado avanzado
Este proyecto se centra en el desarrollo de metodologías innovadoras para la selección asistida por marcadores y la diferenciación varietal en melón y fresa.
-
Presentamos la plataforma Ecoefficacy en Fruit Attraction
Participamos en la próxima edición de Fruit Attraction con una ponencia científico-técnica titulada «Plataforma Ecoefficacy: Evaluación de la eficacia y modo de acción de productos bioestimulantes y agentes de biocontrol»
-
Estudios Genéticos GWAS: herramienta clave para desarrollar cultivos más resistentes y productivos
Los análisis genéticos GWAS se consolidan como herramienta clave para desarrollar cultivos más resistentes y productivos, al identificar las regiones del ADN responsables de sus características.
-
Plataforma Ecoefficacy
La plataforma Ecoefficacy, desarrollada por el equipo científico de ValGenetics, está diseñada para seleccionar y validar de manera intuitiva la eficacia de la capacidad bioestimulante y/o de biocontrol de sustancias y microorganismos u otros agentes de aplicación en la agricultura.
-
Resultados del proyecto Botvid-SENSOR
El proyecto Botvid-SENSOR ha logrado avances significativos en la detección temprana de Botrytis cinerea en viñedos, con la creación de un sensor portátil validado por el sector agrícola, optimizando el manejo de la enfermedad y abriendo puertas a oportunidades comerciales en el ámbito biotecnológico.
-
Avances en el proyecto Botvid-SENSOR
Llegando al final del proyecto se ha conseguido disponer de tejido infectado, se están poniendo a punto el sensor basado en sRNAs, se están validado los prototipos y se está abordanndo el estudio de la escalabilidad.
-
BotVidSENSOR, el proyecto para detectar podredumbre gris en la vid
ValGenetics participa en el proyecto BotVidSENSOR, que tiene por objetivo el desarrollo de un sensor portátil para la detección temprana, rutinaria y de bajo coste de Botrytis cinerea en el viñedo.
- Sello Pyme innovadora desde 2016
- Modelo empresarial reconocido en el programa BioAnces para Bioemprendedores (Genoma España, CEEI)
- Entidad co-financiada por el Instituto Valenciano de Finanzas (IVF), el Instituto Valenciano de Competitividad Empresarial (IVACE), el Centro para el Desarrollo Tecnológico Industrial (CDTI, NEOTEC), la Empresa Nacional de Innovación (ENISA) y el Fondo Social Europeo a través del programa Torres Quevedo (MICINN).
- Laboratorio incluido en el Catálogo de laboratorios de seguridad alimentaria y ambiental de la Conselleria de Sanitat, Direcció General de Salut Pública de la Generalitat Valenciana (GVA)
- Instalaciones autorizadas para la actividad con fines de ensayo o científicos con virus, bacterias y hongos de cuarentena (Sanitat Vegetal, GVA)
- Laboratorio autorizado para análisis fitopatológicos a terceros de patógenos y plagas presentes y de cuarentena, nocivos para los cultivos (Sanitat Vegetal, GVA)
- Laboratorio autorizado para el ensayo con organismos nocivos para los vegetales presentes o de cuarentena (Sanitat Vegetal, GVA)
- Autorización oficial para el manejo y uso confinado de organismos modificados genéticamente (OMG) (Comité Oficial de Control de OMGs, Ministerio de Agricultura, Pesca y Alimentación, GVA)
- Espacio de invernadero aprobado para estación de cuarentena (Ministerio de Agricultura, Pesca y Alimentación, Sanitat Vegetal, GVA)
- Empresa inscrita en el Registro de Proveedores de Semillas y Plantas de Vivero y en el Registro de Productores, Comerciantes e importadores (Conselleria de Agricultura, Medioambiente, Cambio Climático y Desarrollo Rural, GVA)
Localización y contacto